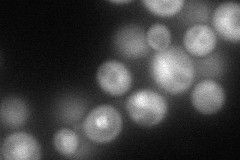
YJL074C
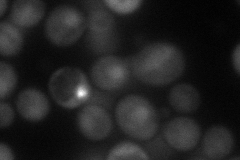
YJL074C
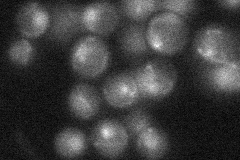
YJL074C
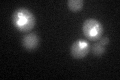
YJL074C
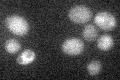
YJL074C

View description
Subunit of the multiprotein cohesin complex required for sister chromatid cohesion in mitotic cells; also required, with Rec8p, for cohesion and recombination during meiosis; phylogenetically conserved SMC chromosomal ATPase family member
Localization:
Intensity:
Fold change:
Significance:
-
C’ GFP library in SD

nucleus34.53 -
N' NOP1pr-GFP in SD
cytosol,nucleus106.27 -
N' TEF2pr-mCherry in SD
nucleus66.2231 -
N' NATIVEpr-GFP in SD
punctate,nucleus24.384 -
N' TEF2pr-VC and Cyto-VN in SD

#N/A0 -
C’ GFP library in SD+DTT
nucleus31.10.9No -
C’ GFP library in SD+H2O2

nucleus34.130.98No -
C’ GFP library in Starvation Media
nucleus24.210.7Yes -
C’ GFP library on the background of Pup2-DaMP

nucleus -
C’ GFP library on the background of CCT mutant

nucleus30.20570.874567No
